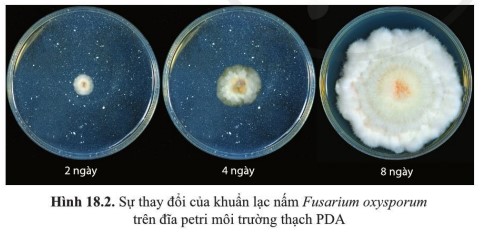
Quan sát hình 18.2 và nhận xét sự thay đổi của khuẩn lạc nấm

Hướng dẫn giải câu hỏi 1 trang 109 SGK Sinh 10 thuộc Bài 18: Sinh trưởng và sinh sản ở vi sinh vật - Sinh học lớp 10 Cánh diều.
Câu hỏi
Quan sát hình 18.2 và nhận xét sự thay đổi của khuẩn lạc nấm (quần thể nấm) Fusarium oxysporum theo thời gian. Vì sao có sự thay đổi này?
Trả lời
- Nhận xét sự thay đổi của khuẩn lạc nấm (quần thể nấm) Fusarium oxysporum theo thời gian: Khuẩn lạc của nấm lan rộng và phủ khắp bề mặt đĩa petri theo thời gian.
- Giải thích: Sự thay đổi kích thước khuẩn lạc là do quần thể nấm sinh sản nhanh tăng lên về số lượng tế bào.
-/-
Trên đây là hướng dẫn câu hỏi 1 trang 109 SGK Sinh 10 Cánh diều :"Quan sát hình 18.2 và nhận xét sự thay đổi của khuẩn lạc nấm (quần thể nấm) Fusarium oxysporum theo thời gian. Vì sao có sự thay đổi này?". Đừng quên tham khảo thêm các câu hỏi trong trọn bộ Giải sinh 10 Cánh diều mà chúng tôi đã tổng hợp.
